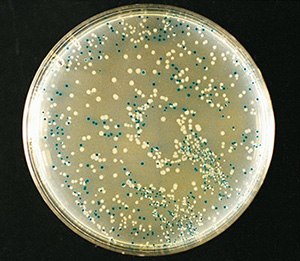
Blue-white color selection of recombinant bacteria using X-gal.

Blue-White Screening & Protocols for Colony Selection
Identification of Recombinant Bacteria
Blue-white screening is a rapid and efficient technique for the identification of recombinant bacteria. It relies on the activity of β-galactosidase, an enzyme occurring in E. coli, which cleaves lactose into glucose and galactose.
Disrupting the LacZ Gene
The presence of lactose in the surrounding environment triggers the lacZ operon in E. coli. The operon activity results in the production of β-galactoisdase enzyme that metabolizes the lactose. Most plasmid vectors carry a short segment of lacZ gene that contains coding information for the first 146 amino acids of β-galactosisdase. The host E. coli strains used are competent cells containing lacZΔM15 deletion mutation. When the plasmid vector is taken up by such cells, due to α-complementation process, a functional β-galatosidase enzyme is produced.
The plasmid vectors used in cloning are manipulated in such a way that this α-complementation process serves as a marker for recombination. A multiple cloning site (MCS) is present within the lacZ sequence in the plasmid vector. This sequence can be nicked by restriction enzymes to insert the foreign DNA. When a plasmid vector containing foreign DNA is taken up by the host E. coli, the α-complementation does not occur, therefore, a functional β-galactosidase enzyme is not produced. If the foreign DNA is not inserted into the vector or if it is inserted at a location other than MCS, the lacZ gene in the plasmid vector complements the lacZ deletion mutation in the host E. coli producing a functional enzyme.
How Does Blue White Screening Work?
For screening the clones containing recombinant DNA, a chromogenic substrate known as X-gal is added to the agar plate. If β-galactosidase is produced, X-gal is hydrolyzed to form 5-bromo-4-chloro-indoxyl, which spontaneously dimerizes to produce an insoluble blue pigment called 5,5’-dibromo-4,4’-dichloro-indigo. The colonies formed by non-recombinant cells, therefore appear blue in color while the recombinant ones appear white. The desired recombinant colonies can be easily picked and cultured.
Isopropyl β-D-1-thiogalactopyranoside (IPTG) is used along with X-gal for blue-white screening. IPTG is a non-metabolizable analog of galactose that induces the expression of lacZ gene. It should be noted that IPTG is not a substrate for β-galactosidase but only an inducer. For visual screening purposes, chromogenic substrate like X-gal is required.

Figure 1.A schematic representation of a typical plasmid vector that can be used for blue-white screening.

Figure 2.A schematic representation of a typical blue-white screening procedure.
Blue-White Screening Products (Materials)
Protocols for Blue-White Screening
The complete protocol of blue-white screening includes 3 important steps:
- Ligation: ligation of foreign DNA into MCS of the plasmid vector
- Transformation: introduction of plasmid vector with foreign DNA insert into competent E. coli
- Screening: blue-white screening to identify recombinant bacterial colonies
Ligation
We offer the following ready-to-use expression vectors that can be used for stable as well as transient expression systems. These FLAG-fusion constructs have origins of replication for propagation in both bacterial and mammalian cells.
Materials required
The following is the reaction setup for ligation
- Add all the above components into a clean reaction tube.
- Incubate for 30 minutes at 25 °C (can be performed in a thermo cycler).
- Purify DNA using PCR clean-up column and elute in approximately 50 µL.
- Transform 0.1-10 ng of the ligation product into chemical or electrocompetent cells that are compatible with the vector.
Transformation
High quality plasmid is essential for the transformation procedure. The following kits isolate and purify high quality plasmid suitable for transformation.
The detailed protocol for transformation using chemical or electrocompetent cells can be found here.
Screening
We offer a range of chromogenic substrates that aid screening of recombinant bacteria. Some products may be used to spread on LB agar plates (screening protocol 1), while the others are incorporated into the microbial medium (screening protocol 2). The products are used along with IPTG wherever required. The protocols for both the procedures are given below.
Screening protocol 1 (applicable for product numbers B6650, 16658, B2904, B3928, 16669, B8931)
- Spread 40 µL or appropriate amount of stock solution of chromogenic substrate and 10 µL of IPTG solution on LB agar plates using a sterile spreader (addition of IPTG when using product number B3928 is not required as it already contains IPTG).
- The plates should include those with appropriate antibiotic and without antibiotic as controls.
- Leave the plates to dry in laminar flow chamber with lids slightly open.
- Spread 10-100 µL of transformed E. coli cells onto the LB agar plates using sterile spreader.
- Incubate the plates at 37 °C for 24-48 hours.
- Blue and white colonies appear on the agar surface. Select the recombinant cells in the white colonies to culture.
Screening protocol 2 (applicable for product numbers S7313, S9811, C4478)
- Prepare LB agar by weighing appropriate powder medium, agar and water in a sterile flask. Alternatively, weigh appropriate amount of C4478 and add to water in a sterile flask.
- Add 300 mg/L of product numbers S7313 and S9811, and 500 mg/L of ferric ammonium citrate (product number F5879) to the medium before autoclaving. Avoid this step if C4478 is being used.
- Autoclave the medium and cool just enough to be able to handle the flask.
- Add appropriate concentration of selected antibiotic to the medium.
- Pour approximately 25-30 mL of the LB agar into sterile plates and allow to set with lids slightly open.
- Spread 10-100 µL of transformed E. coli cells onto the LB agar plates using sterile spreader.
- Incubate the plates at 37 °C for 24-48 hours.
- Blue and white colonies appear on the agar surface. Select the recombinant cells in the white colonies to culture.
Figure 3.Blue-white color selection of recombinant bacteria using X-gal.
Limitations of blue-white screening
- The blue-white technique is only a screening procedure; it is not a selection technique.
- The lacZ gene in the vector may sometimes be non-functional and may not produce β-galactosidase. The resulting colony will not be recombinant but will appear white.
- Even if a small sequence of foreign DNA may be inserted into MCS and change the reading frame of lacZ gene. This results in false positive white colonies.
- Small inserts within the reading frame of lacZ may produce ambiguous light blue colonies as β-galactosidase is only partially inactivated.
References
To continue reading please sign in or create an account.
Don't Have An Account?